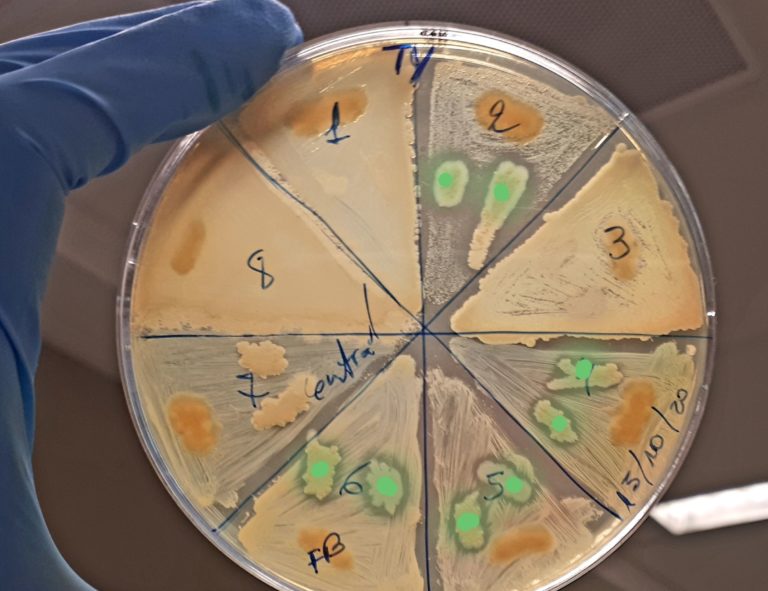
Cervelli al Sud, da Siviglia a Napoli per lo studio di microorganismi marini

Brains to South è il bando promosso dalla Fondazione CON IL SUD, grazie al quale ricercatori stranieri o italiani, che svolgevano la loro attività da almeno 3 anni all’estero o nel Centro – Nord stanno avendo l’opportunità di condurre un progetto di ricerca sotto la propria responsabilità, senza supervisori, in un Ente del Sud Italia. Il bando è giunto alla quarta edizione, per la quale sono stati messi a disposizione complessivamente 4 milioni di euro con un massimo di 400 mila euro a progetto.
‘L’obiettivo di Brains to South’ afferma Carlo Borgomeo Presidente della Fondazione CON IL SUD ‘non è contrastare la fuga di ‘cervellì, ma attrarre le menti migliorì.
Abbiamo intervistato alcuni dei vincitori che ci hanno raccontato la loro storia personale e professionale, i loro progetti di ricerca, insieme alle motivazioni che li hanno spinti a partecipare al bando.
Maria Paulina Corral Villa, ecuadoriana, proviene dall’Università di Siviglia e sta svolgendo il suo progetto di ricerca ‘BLUEPHARMA: OMICS approach for marine drug discovery’ presso l’Università Federico II a Napoli.
‘In questo progetto – spiega – studiamo microorganismi marini con attività biosintetica rilevata in laboratorio ‘in vitrò per la produzione di nuovi composti come possibili farmaci del futuro per combattere malattie come il cancro e per la produzione di antibiotici capaci di contrastare l’antibiotico-resistenza. La conoscenza della biodiversità microbica degli ambienti marini – continua – viene approfondito dalle scienze ‘omichè, suffisso che indica lo studio totale e massivo di un determinato sistema biologico. Nell’ambito del progetto BluePharma, l’approccio è multi-omico, ciò è utilizza e combina vari strumenti come la genomica per lo studio di geni presenti in microorganismi coinvolti nella attività antimicrobica e antitumorale rilevata ‘in vitrò; la metagenomica per la totalità di geni presenti nella microbiota marina; e la proteomica e metabolomica per valutare la capacità di espressione di proteine e metaboliti. Le integrazioni e le relazioni dei dati che derivano da questi studi ci danno una risposta biologica da una perspettiva globale ed attualizzata alle nuove sfide della resistenza antibiotica e al fabbisogno di nuovi composti antimicrobici ed antitumorali. La nostra ricerca è rispettosa dell’ambiente e segue le linee del patto verde europeo ‘Green deal’ in particolare nei nostri protocolli minimizziamo l’uso di plastiche e solventi, in questo modo riduciamo l’impatto nella natura con una produzione eco-sostenibile di composti candidati a nuovi farmaci ‘Bio-based’.
Paulina Corral, è un’amante della scienza ed è desiderosa di conoscere il mondo e le sue culture. Ha intrapreso la carriera scientifica avendo ben chiaro di voler diventare una ricercatrice. ‘Ho conseguito la laurea in Microbiologia presso la Pontificia Università Cattolica dell’Equador a Quito – racconta – ma questo titolo è stato solo l’inizio di una lunga strada per il raggiungimento dei miei obiettivi nella ricerca e, ancora più fondamentale, la realizzazione come donna con canoni diversi in un ambiente più egualitario e di libertà. In Spagna ho avuto l’opportunità di conseguire prima un Master in Biotecnologia e poi il Dottorato in Biologia Molecolare e Biomedicina presso l’Università di Siviglia. Un meraviglioso periodo, cui ha fatto seguito i post dottorati presso il Consiglio Nazionale della Ricerca (CNR) in Italia e presso l’ University of Central Florida di Orlando negli Stati Uniti. Due realtà differenti ma entrambe estremamente formative. Adesso conduco il mio progetto di ricerca BluePharma presso il Dipartimento di Biologia dell’Università di Napoli Federico II come ricercatrice principale, e questa è la mia sfida e anche la mia motivazione.
Il suo progetto di ricerca era stato avviato all’Università di Siviglia. Perchè?
In un progetto di ricerca è essenziale la scelta del mentore con cui condurlo: nel mio caso la scelta si è basata sul livello di eccellenza in materia di microrganismi estremi, dove il Professor Antonio Ventosa è un referente mondiale nello studio degli ambienti ipersalini e dei loro microrganismi alofili. Il suo gruppo di ricerca si trova presso il Dipartimento di Microbiologia e Parassitologia della Facoltà di Farmacia. Si tratta di un gruppo altamente competitivo con elevate esigenze ma in un ambiente piacevole e che invogliava a dare il meglio di sè. E’ qui che ho ottenuto il PhD ed ho raggiunto la maggior parte dei miei obiettivi.
Perchè la scelta di partecipare al bando?
Brains To South ha delle caratteristiche eccezionali, tra le quali la captazione di talenti ad alta qualificazione senza restrizioni di nazionalità, cosa che permette ai vincitori realizzare carriere indipendenti presso centri di ricerca e Università nel sud di Italia. Già questo ti fa partire con un grande entusiasmo, ma il carattere competitivo del bando lo rende un’enorme sfida, ed è precisamente questo che spinge a sviluppare un progetto di ricerca di eccellenza che impatti nella società, promuovendo lo sviluppo del territorio e della scienza – che in sè non ha frontiere: una coniugazione perfetta che mi ha portato a mettere tutti i miei sforzi e le mie conoscenze per svilupparlo al meglio. Un altro importante elemento è che permette di creare un proprio gruppo di ricerca, praticamente il sogno di un giovane ricercatore…. mettere in atto le capacità scientifiche e di gestione maturate nella formazione acquisita nel pregresso per condurre un progetto di ricerca nel ruolo di ricercatore principale.
Perchè l’Italia?
‘Chi non la sognerebbè sarebbe la risposta più adatta. L’Italia è considerata uno dei Paesi più belli del mondo e possiede università e centri di ricerca di fama mondiale. Sono convinta che l’attrazione di talento sia uno strumento essenziale per lo sviluppo di una società e nel caso di Brain to South, che propone a uno straniero o italiano di sviluppare un proprio progetto, finanziato tutto e quello che devi fare è solamente scegliere la host institution… semplicemente fa la valigia.
Quali i risvolti di questa scelta a livello personale e lavorativo?
Personalmente è stata una scelta importante, dopo avere lavorato e vissuto tante esperienze in altri Paesi, adesso mi trovo su una strada più stabile in un paese meraviglioso come l’Italia. Svolgere le attività quotidiane in un ambiente piacevole e pittoresco dove poter godere del cibo e della bellezza paesaggistica oltre a tante altre qualità di questa terra non ha prezzo. A livello lavorativo è stata una spinta significativa in questa fase della mia carriera, godo dei benefici impliciti di essere indipendente e di gestire il progetto in piena autonomia. Come ricercatore principale viene pubblicato il nome, si creano relazione scientifiche con altri gruppi e si può facilmente innovare. Nell’aspetto sperimentale provo grande soddisfazione e sono orgogliosa di vedere come si stiano generando dei risultati nonostante le difficoltà di questi tempi. Fortunatamente ho il supporto amministrativo e scientifico dei membri del dipartimento. Insomma, i vantaggi che aiutano a raggiungere gli obiettivi programmati sono tanti e di conseguenza la carriera si potenzia e si arricchisce.
Quali relazioni con le Università all’estero?
Attualmente manteniamo la collaborazione con il Wisconsin Institute for Discovery negli Stati Uniti nell’ambito del programma internazionale per la scoperta di antibiotici Tiny Earth. In Spagna con l’Università Miguel Hernandez di Alicante per il supporto scientifico nella metagenomica dei microorganismi marini; a Barcelona con l’Institute for Global Health, ISGlobal e l’Università di Barcellona nel ambito del consorzio europeo Superbug Awareness for Education (SAFE); il mio centro d’origine, l’Università di Siviglia per supporto scientifico in genomica e metagenomica; e non poteva mancare il partner di BluePharma, la Fondazione MEDINA di Granada per l’identificazione di molecole e produzione dei composti. Nei prossimi mesi, stabiliremo la collaborazione con altri gruppi di ricerca internazionali per gli studi di proteomica, metabolomica ed ecologia microbica.
Quale futuro immagina?
Il mondo ha bisogno di ricerca e non si può fermare perchè la scienza non ha limiti. Mi auspico di ottenere risultati di sempre maggior interesse e impatto sulla scienza e sul buon andamento della medicina e dell’ecologia mondiale, pertanto di dirigere un laboratorio o magari un centro di ricerca con un gruppo costituito da validi ed entusiasti ricercatori con vari progetti a l’avanguardia, affrontando le tante sfide future. La base sarà sempre quella di compiere una ricerca sostenibile e coinvolgere alla società per potenziare l’effetto.
(ITALPRESS).